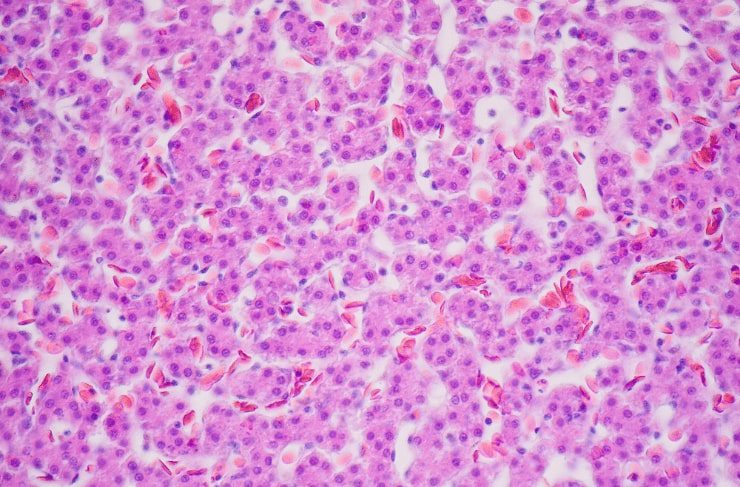

Historically, primary hepatocytes have been the preferred in vitro model for assessing drug-induced expression of drug metabolizing enzymes. There are two major limitations to the use of human liver cells or their derivatives. First, there are currently limited sources of fresh human hepatocytes worldwide and, when available, they often suffer from low viability and high batch -to-batch variability. Second, the freezing process used to preserve primary hepatocytes and the transformation process needed to make stable and proliferating cell lines results in changes in cell differentiation, proliferation, and metabolic processes.
upcyte® Hepatocytes
Immortalized human heptoma (i.e., HepG2) and hepato-carcinoma cell lines are sometimes used owing to their unlimited proliferative potential. However, a serious limitation to using transformed cell lines is their decreased, or absent, expression of hepatocyte differentiation markers. These include nuclear receptors and other xenobiotic-sensing receptors and, hence, their target genes (e.g., CYPs) whose expression are critical to correctly assessing the potential liability of induced drug-drug interactions.
Using these model systems has led to an inability to predict hepatotoxicity at the preclinical stage. This has been a key reason for xenobiotic-induced liver injury being a major cause of human morbidity and mortality.
About upcyte® Hepatocytes
upcyte® technologies has developed a novel technique which allows for the generation of human hepatocyte cultures with the ability to proliferate while maintaining many differentiated functions. upcyte® hepatocytes, which are human donor-derived hepatocytes established by upcyte® technologies GmbH, have the attributes of limited proliferation while maintaining their native high levels of constitutive and inducible xenobiotic metabolizing enzyme activities.
Like primary hepatocytes, confluent cultures of upcyte® hepatocytes express liver-specific proteins, produce urea, and store glycogen. Importantly, the induction profiles of cytochrome p450 (CYP) enzyme activities are similar to those of the primary hepatocytes. Thus, upcyte® hepatocytes combine the characteristics and advantages of primary hepatocytes with the added practical advantage of having access to the same donor cells for use in iterative, large-scale experiments over extended periods – making them ideal for drug discovery.
Benefits of upcyte® Hepatocytes
- upcyte® hepatocytes did not form colonies in soft agar and are not immortalized ancorage-independent cells.
- Confluent cultures expressed liver-specific proteins, produced urea, and stored glycogen.
- CYP activities were low but similar to that in 5-day cultures of primary human hepatocytes. CYP1A2 and CYP3A4 were inducible; moreover, upcyte® hepatocytes predicted the in vivo induction potencies of known CYP3A4 inducers. Placing cells into 3D culture increased their basal CYP2B6 and CYP3A4 basal activities and induction responses.
- Phase 2 activities (UGTs, SULTs, and GSTs) were comparable to activities in freshly isolated hepatocytes.
- upcyte® hepatocytes were markedly more sensitive to the hepatotoxin, α-amanitin, than HepG2 cells. The cytotoxicity of aflatoxin B1 was decreased in upcyte® hepatocytes by co-incubation with the CYP3A4 inhibitor, ketoconazole. upcyte® hepatocytes differentiated between ten hepatotoxic and eight non-hepatotoxic compounds.
- In conclusion, upcyte® hepatocyte cultures have a differentiated phenotype and exhibit functional phase 1 and 2 activities. These data support the use of upcyte® hepatocytes for CYP induction and cytotoxicity screening.
upcyte® Hepatocytes are used by INDIGO Biosciences for these reasons, through commercial license agreement with upcyte® technologies, to provide our customers with the most reliable science and platforms to accelerate scientific decisions.
